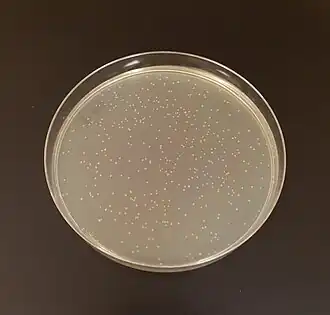

Bibliotheek (moleculaire biologie)
In de moleculaire biologie verwijst een DNA-bibliotheek (Engels: DNA library) meestal naar een verzameling DNA-fragmenten die in een vector (zoals een plasmide of bacteriofaag) zijn gekloneerd en opgeslagen in een gastheercel, zoals E. coli.[1] Deze bibliotheek vertegenwoordigt genetisch materiaal van een organisme of een specifieke selectie daarvan. Moleculaire bibliotheken maken het mogelijk om grote hoeveelheden genetisch materiaal te kloneren en systematisch te onderzoeken.
Er zijn verschillende soorten moleculaire bibliotheken, afhankelijk van het doel. Twee veelgebruikte typen zijn de genomische bibliotheek en de cDNA-bibliotheek. Een genomische bibliotheek bevat willekeurige stukjes van het volledige genoom van een organisme. Dit betekent dat ook niet-coderende regio’s zoals introns, regulerende elementen en junk-DNA zijn opgenomen. Elk fragment wordt geligeerd in een gewenste vector en gekloneerd (vermenigvuldigd) in een gastheercel. De bibliotheek kan dan gescreend worden, bijvoorbeeld met een moleculaire probe, om de kloon van interesse te vinden. Genoombibliotheken zijn onder meer gebruikt om een genoomsequentie te ontrafelen (sequencing).
Een cDNA-bibliotheek wordt gemaakt uit mRNA, dat eerst via reverse-transcriptase wordt omgezet in cDNA. Dit betekent dat de bibliotheek alleen de genen bevat die op het moment van isolatie actief tot expressie werden gebracht in het betreffende weefsel of de cel. Een cDNA-bibliotheek is bijzonder waardevol voor onderzoekers die willen weten welke genen tot uiting komen in een bepaalde biologische toestand, bijvoorbeeld tijdens infectie, stress of ontwikkeling. Ze worden ook gebruikt om nieuwe genen te ontdekken (functionele genomica), of recombinante eiwitten te produceren.
Zie ook
Bronnen
- (nl) Schuit, F.C (2000). Medische biochemie. Bohn Stafleu Van Loghum, pp. 435-436. ISBN 90-313-3020-5.
- ↑ (en) King RC, Mulligan PK, Stansfield WD. (2013). A Dictionary of Genetics, 8th. Oxford University Press, pp. 190. ISBN 978-0-19-976644-4.